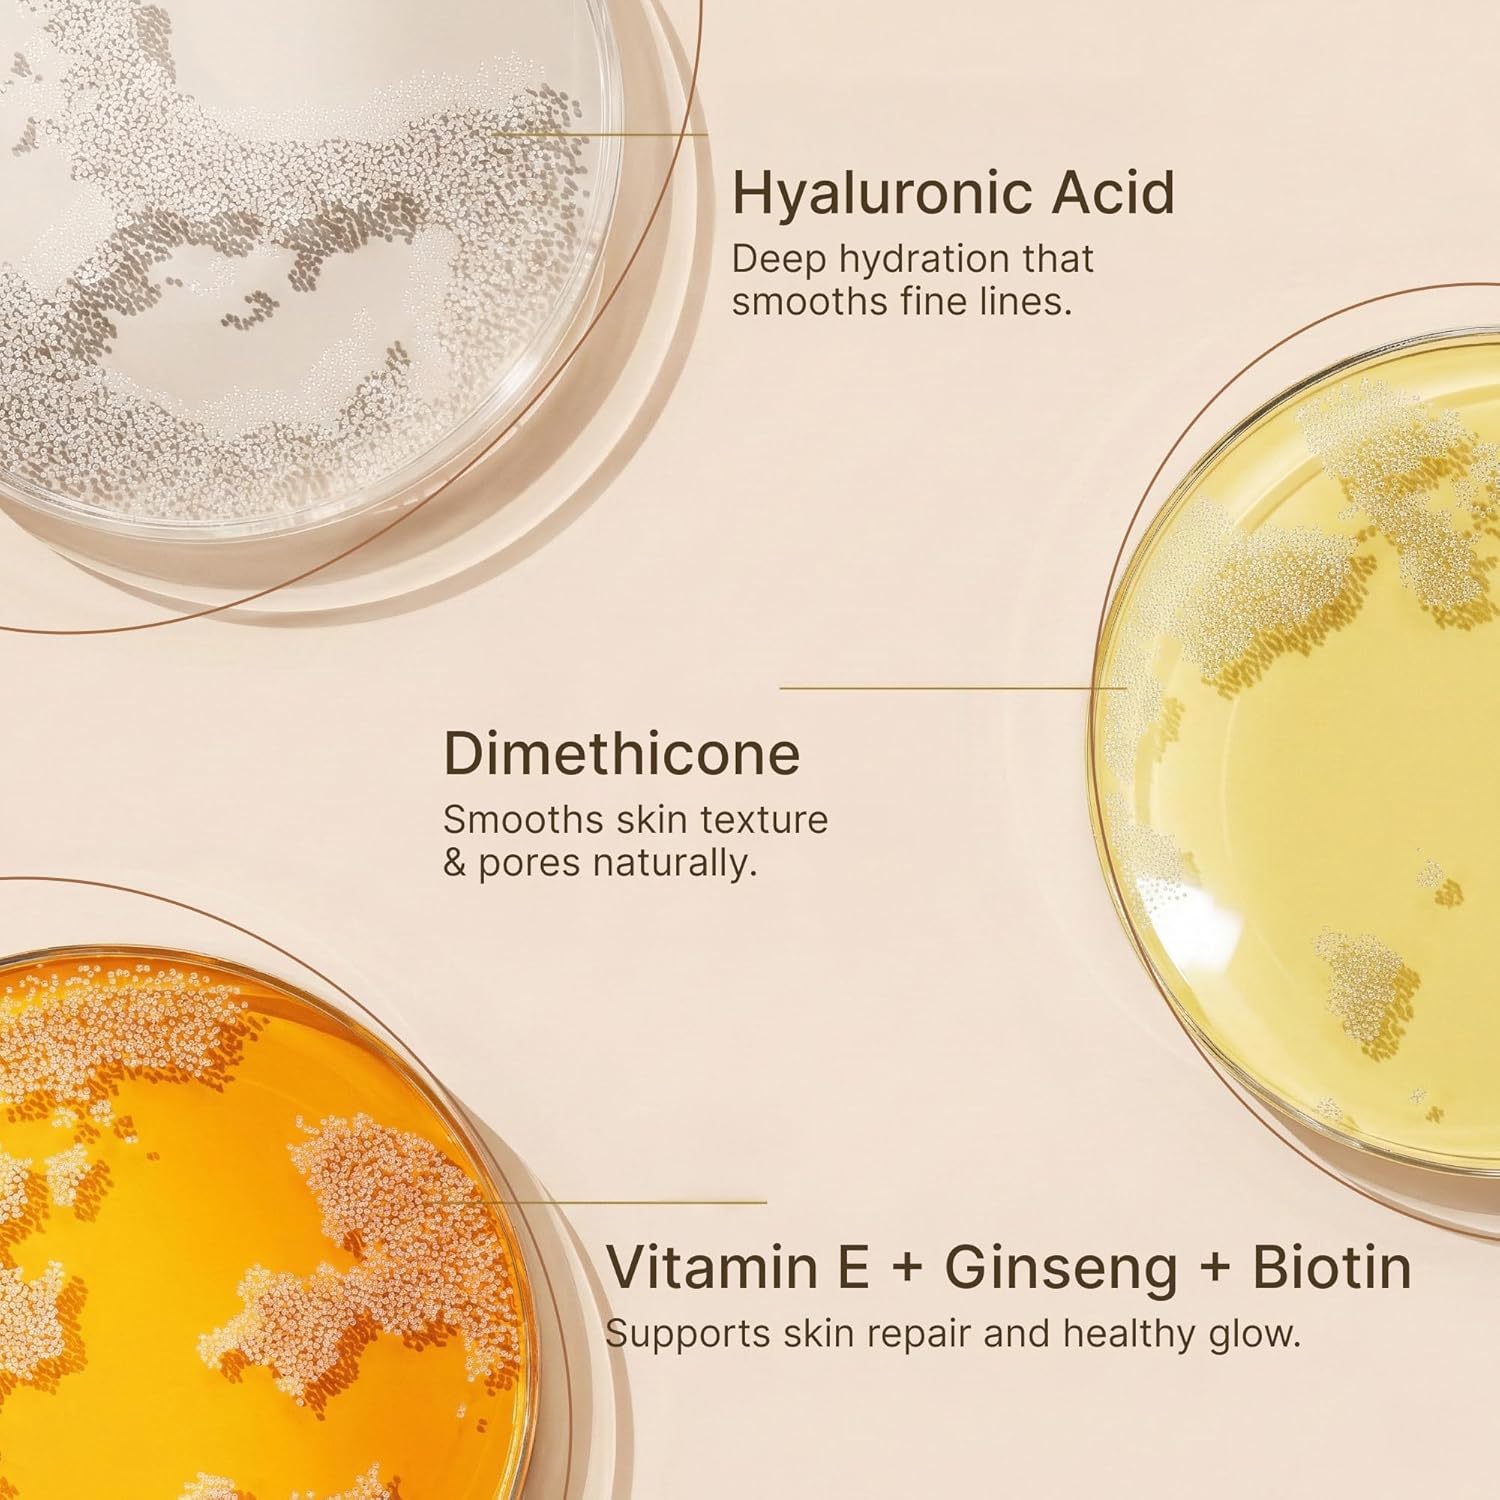
LUVIE Glow Cushion Foundation - Hydrating BB Cream Cushion with Hyaluronic Acid, Aloe & Vitamin E -Dewy Finish Buildable Full Coverage Foundation, SPF 30 Long-Lasting Makeup for All Skin Types - WARM

LUVIE Glow Cushion Foundation - Hydrating BB Cream Cushion with Hyaluronic Acid, Aloe & Vitamin E -Dewy Finish Buildable Full Coverage Foundation, SPF 30 Long-Lasting Makeup for All Skin Types - WARM
$39.99
Price when purchased online
Free shipping
Free 30-day returns
Sold and shipped by v1.seanmas.com.au
We aim to show you accurate product information. Manufacturers, suppliers and others provide what you see here.
$39.99
Price when purchased online
Free shipping
Free 30-day returns
Sold and shipped by v1.seanmas.com.au
Free 30-day returns Details
Product details
| Management number | 215595379 | Release Date | 2026/04/12 | List Price | $16.00 | Model Number | 215595379 | ||
|---|---|---|---|---|---|---|---|---|---|
| Category | |||||||||
- SKINCARE-INFUSED CUSHION FOUNDATION: Infused with Hyaluronic Acid, Aloe Vera, Rose Extract, and Vitamin E to hydrate, soothe, and nourish your skin while providing beautiful coverage. Our hydrating foundation supports balanced moisture and helps keep skin looking healthy and radiant all day.
- BUILDABLE FULL COVERAGE: This cushion BB foundation provides smooth, buildable coverage that helps blur pores, conceal blemishes, and even skin tone while maintaining a natural finish foundation look. Perfect for those who want breathable foundation makeup that enhances the skin without feeling heavy or cakey.
- LIGHTWEIGHT SECOND-SKIN FEEL: This lightweight cushion foundation delivers a breathable second-skin feel with a beautiful dewy finish foundation glow. The hydrating formula of our moisturizing foundation blends effortlessly to create radiant, smooth skin while maintaining a natural glow makeup look.
- LONG-LASTING WITH SPF 30: This long lasting foundation provides reliable coverage while helping protect your skin with SPF 30 sun protection. The hydrating foundation formula stays fresh throughout the day, making it ideal for daily makeup routines.
- EASY CUSHION APPLICATION: The innovative cushion compact foundation allows smooth, mess-free application for even makeup coverage. Simply press the sponge into the cushion and gently pat onto the skin for flawless results. This portable cushion foundation compact makes quick touch-ups easy while maintaining a radiant complexion and natural finish foundation look.
| Color | WARM |
|---|---|
| Set Name | WARM |
| Item Form | Cream |
| Skin Tone | All |
| Skin Type | All |
| Brand Name | LUVIE |
| Unit Count | 1.0 Ounce |
| Finish Types | Natural |
| Manufacturer | LUVIE |
| Container Type | Box |
| Sun Protection | 30 Sun Protection Factor (SPF) |
| Number of Items | 1 |
| Product Benefits | Buildable Coverage, Even Skin Tone, Hydrating, Long Lasting, Moisturizing, Pore Blurring |
| Country as Labeled | China |
| Material Type Free | Alcohol Free |
| Additional Features | Dewy Finish, Pore Blurring Effect, Even Skin Tone Coverage, Hydrating Formula, Long Lasting Wear, SPF 30 Protection, Skincare Infused, Breathable Makeup |
| Age Range Description | Adult |
| Contour Shade Undertone | Ivory, Warm, Brunet Brown |
| Recommended Uses For Product | Face |
| Global Trade Identification Number | 00860015366214 |
Correction of product information
If you notice any omissions or errors in the product information on this page, please use the correction request form below.
Correction Request Form